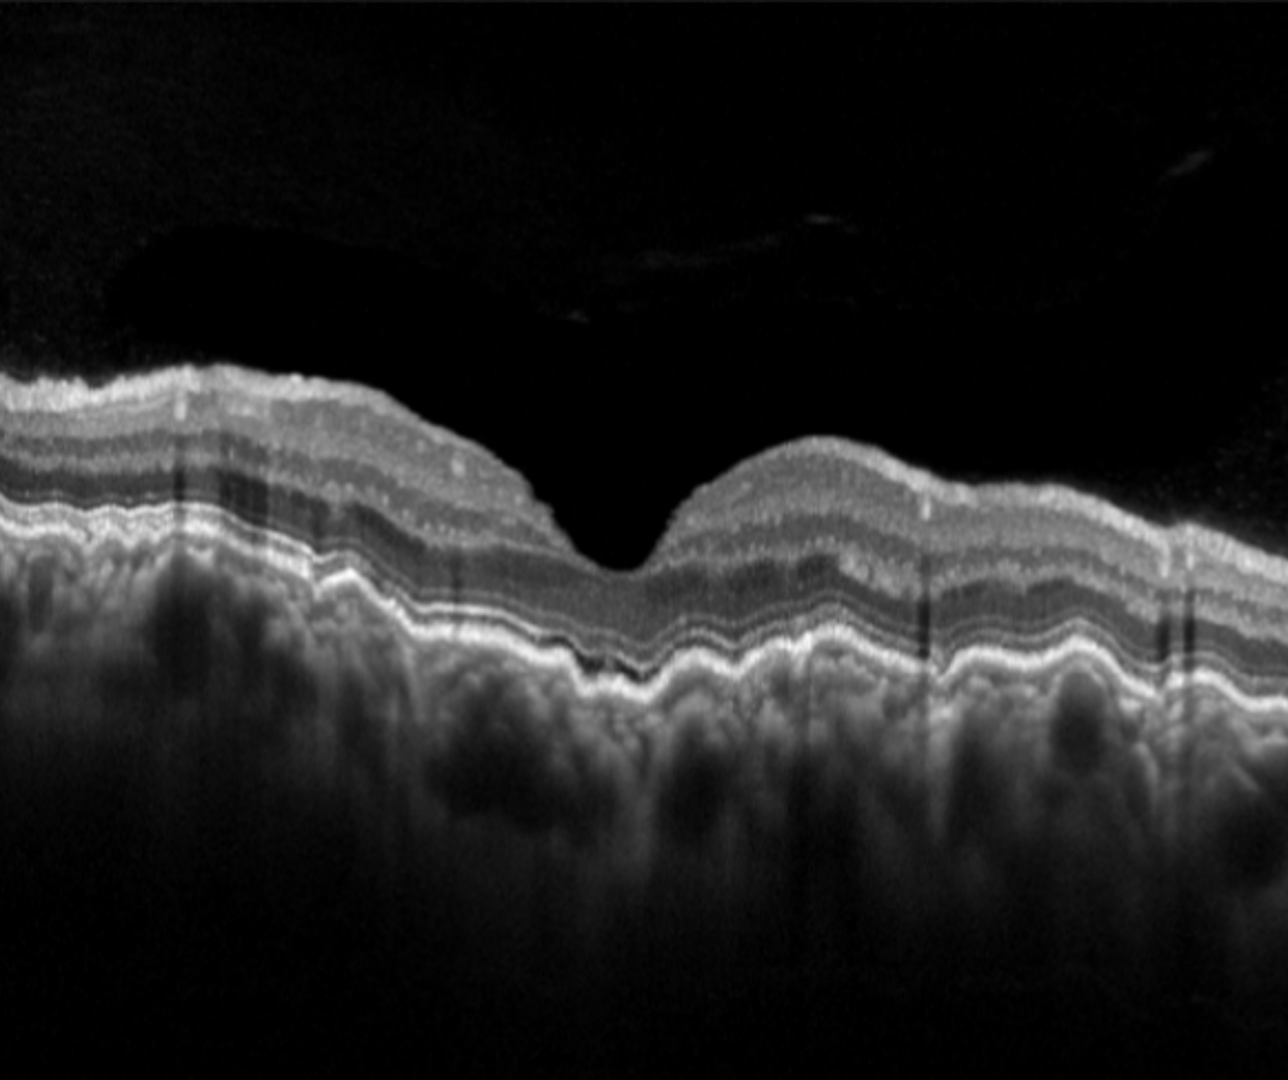

Overview
Choroidal folds are undulations of the outer retina (Bruch’s membrane, RPE and neurosensory retina) and the choroid. They are best appreciated on a vertical OCT line scan and may be distinguished from retinal folds caused by an epiretinal membrane using OCT.
Chorioretinal folds appear on retinal examination as a series of lines (typically alternating between yellow and dark).
They have been associated with a range of ocular conditions including high hyperopia, ocular hypotony, uveal effusion syndrome, posterior scleritis and choroidal or orbital tumours and some are considered idiopathic.
Case Examples
-
Case 1: Long-standing choroidal folds
A 47 year old asymptomatic male with best corrected visual acuity of 6/6 (20/20) in the left eye. The right eye was unremarkable. Refraction was +0.50 DS in the right eye and +2.75 DS in the left.
In this case the choroidal folds were long-standing, however further testing to exclude a retrobulbar mass is still advisable.
-
Case 2: Choroidal folds associated with posterior scleritis
A 65 year-old male with type 2 diabetes, diagnosed 2 years ago. He had a steroid injection 2 months ago due to back pain and has pending surgery. Pinhole visual acuity was 6/7.5 (20/25) in each eye.
Retinal photograph and red-free image (right eye)
More infoOptos Widefield Images (right and left eye)
More infoOptos Widefield Green-Separation Images
More infoFundus autofluorescence (FAF) images
More infoSpectralis OCT line scans through mid-periphery (right and left eye)
More infoB-scan ultrasound (right eye, vertical)
More info
Differential Diagnosis
References
Grosso, D., Borrelli, E., Sacconi, R., Bandello, F., & Querques, G. (2020). Recognition, Diagnosis and Treatment of Chorioretinal Folds: Current Perspectives. Clinical ophthalmology (Auckland, N.Z.), 14, 3403–3409.


